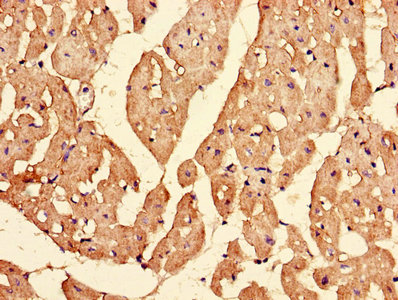

IPO13 Antibody
-
中文名稱:IPO13兔多克隆抗體
-
貨號:CSB-PA011776LA01HU
-
規格:¥440
-
圖片:
-
Western Blot
Positive WB detected in: HEK293 whole cell lysate, Hela whole cell lysate, A549 whole cell lysate
All lanes: IPO13 antibody at 3µg/ml
Secondary
Goat polyclonal to rabbit IgG at 1/50000 dilution
Predicted band size: 109 kDa
Observed band size: 109 kDa -
Immunohistochemistry of paraffin-embedded human heart tissue using CSB-PA011776LA01HU at dilution of 1:100
-
Immunofluorescent analysis of Hela cells using CSB-PA011776LA01HU at dilution of 1:100 and Alexa Fluor 488-congugated AffiniPure Goat Anti-Rabbit IgG(H+L)
-
-
其他:
產品詳情
-
產品名稱:Rabbit anti-Homo sapiens (Human) IPO13 Polyclonal antibody
-
Uniprot No.:
-
基因名:IPO13
-
別名:Imp 13 antibody; Imp13 antibody; Importin-13 antibody; Importin13 antibody; IPO 13 antibody; Ipo13 antibody; IPO13_HUMAN antibody; Kap 13 antibody; Kap13 antibody; Karyopherin 13 antibody; Karyopherin-13 antibody; Karyopherin13 antibody; KIAA0274 antibody; Late gestation lung 2 antibody; Late gestation lung 2 protein antibody; Lgl2 antibody; Ran binding protein 13 antibody; Ran-binding protein 13 antibody; RanBP 13 antibody; RanBP13 antibody
-
宿主:Rabbit
-
反應種屬:Human
-
免疫原:Recombinant Human Importin-13 protein (501-700AA)
-
免疫原種屬:Homo sapiens (Human)
-
標記方式:Non-conjugated
本頁面中的產品,IPO13 Antibody (CSB-PA011776LA01HU),的標記方式是Non-conjugated。對于IPO13 Antibody,我們還提供其他標記。見下表:
-
克隆類型:Polyclonal
-
抗體亞型:IgG
-
純化方式:>95%, Protein G purified
-
濃度:It differs from different batches. Please contact us to confirm it.
-
保存緩沖液:Preservative: 0.03% Proclin 300
Constituents: 50% Glycerol, 0.01M PBS, PH 7.4 -
產品提供形式:Liquid
-
應用范圍:ELISA, WB, IHC, IF
-
推薦稀釋比:
Application Recommended Dilution WB 1:500-1:5000 IHC 1:20-1:200 IF 1:50-1:200 -
Protocols:
-
儲存條件:Upon receipt, store at -20°C or -80°C. Avoid repeated freeze.
-
貨期:Basically, we can dispatch the products out in 1-3 working days after receiving your orders. Delivery time maybe differs from different purchasing way or location, please kindly consult your local distributors for specific delivery time.
-
用途:For Research Use Only. Not for use in diagnostic or therapeutic procedures.
相關產品
靶點詳情
-
功能:Functions in nuclear protein import as nuclear transport receptor. Serves as receptor for nuclear localization signals (NLS) in cargo substrates. Is thought to mediate docking of the importin/substrate complex to the nuclear pore complex (NPC) through binding to nucleoporin and the complex is subsequently translocated through the pore by an energy requiring, Ran-dependent mechanism. At the nucleoplasmic side of the NPC, Ran binds to the importin, the importin/substrate complex dissociates and importin is re-exported from the nucleus to the cytoplasm where GTP hydrolysis releases Ran. The directionality of nuclear import is thought to be conferred by an asymmetric distribution of the GTP- and GDP-bound forms of Ran between the cytoplasm and nucleus. Mediates the nuclear import of UBC9, the RBM8A/MAGOH complex, PAX6 and probably other members of the paired homeobox family. Also mediates nuclear export of eIF-1A, and the cytoplasmic release of eIF-1A is triggered by the loading of import substrates onto IPO13.
-
基因功能參考文獻:
- IPO13 influenced intracellular distribution of CTCF. PMID: 23620300
- IPO13 may contribute to the pathogenesis of pterygium via modulation of K17 and c-Jun. PMID: 23559854
- Imp13 is able to bind and export eIF1A in vivo and that its function is essential. PMID: 23435562
- These results demonstrate an increased expression of IPO13 in endometriosis and endometrial carcinoma. PMID: 22648251
- Data show that expression of IPO13, c-kit, telomerase, caspase3, and CD146 are decreased in endometrial polyps; however, the expression of bcl-2 was increased in polyps compared to the normal endometrial tissue. PMID: 21804459
- IPO13 is uniquely expressed by human limbal basal epithelial cells, and plays an important role in maintaining the phenotype, high proliferative potential, and less differentiation of corneal epithelial progenitor cells. PMID: 19593795
- Imp13 functions in myopodin import and the regulation of this event is critical for normal and abnormal cellular differentiation. PMID: 17828378
- Importin 13 mediates nuclear import of histone fold-containing chromatin accessibility complex heterodimers PMID: 19218565
- IPO13 variation may improve nuclear bioavailability of endogenous glucocorticoids PMID: 19619331
顯示更多
收起更多
-
亞細胞定位:Cytoplasm. Nucleus.
-
蛋白家族:Importin beta family
-
組織特異性:Expressed in fetal brain, heart, intestine and kidney.
-
數據庫鏈接:
Most popular with customers
-
-
YWHAB Recombinant Monoclonal Antibody
Applications: ELISA, WB, IHC, IF, FC
Species Reactivity: Human, Mouse, Rat
-
Phospho-YAP1 (S127) Recombinant Monoclonal Antibody
Applications: ELISA, WB, IHC
Species Reactivity: Human
-
-
-
-
-